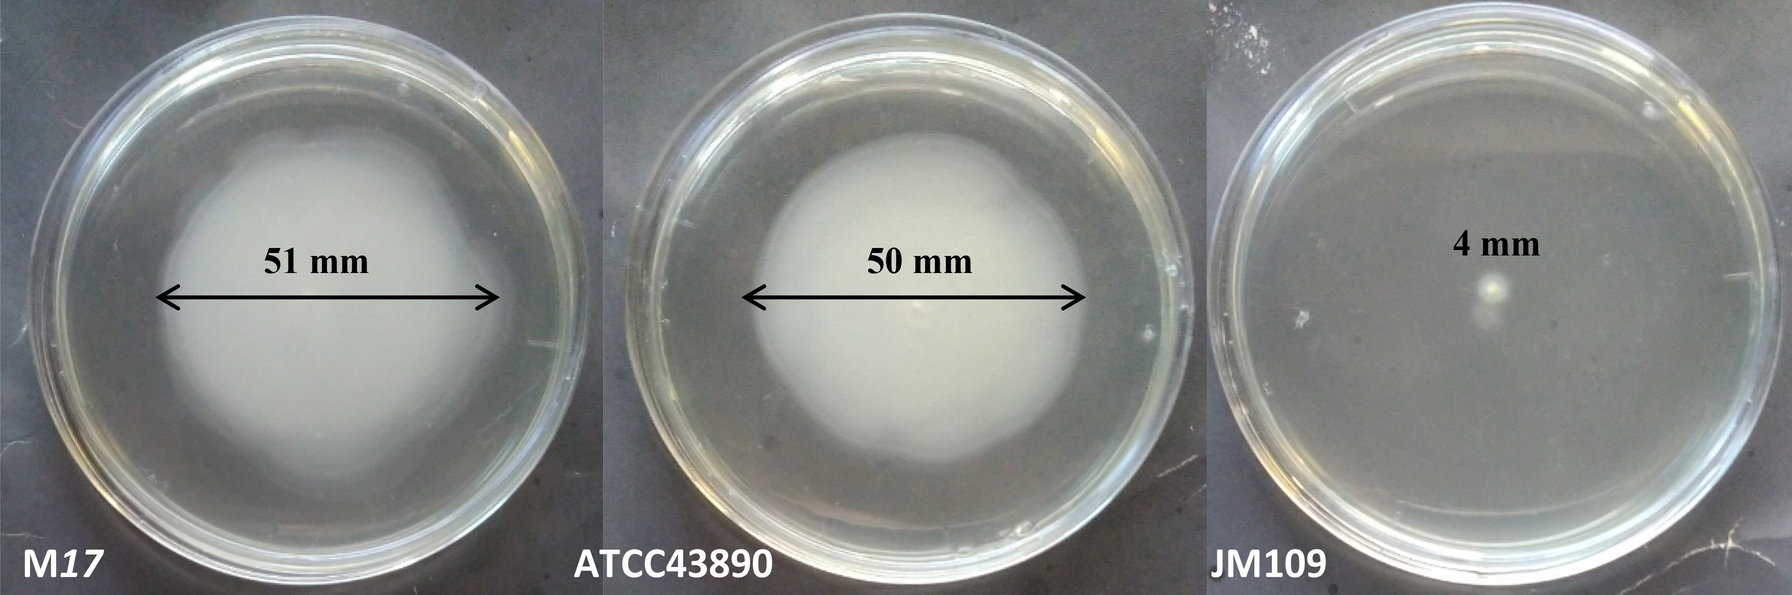
Figure 1

Figure 1
From: Strain specific motility patterns and surface adhesion of virulent and probiotic Escherichia coli

Motility of E. coli strains in a semi-solid agar.
From: Strain specific motility patterns and surface adhesion of virulent and probiotic Escherichia coli
Motility of E. coli strains in a semi-solid agar.